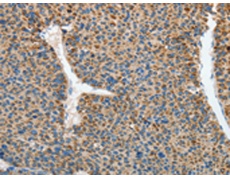
一抗

中文名稱: 兔抗RCAN1多克隆抗體
英文名稱: Anti-RCAN1 rabbit polyclonal antibody
別 名: CSP1; DSC1; RCN1; DSCR1; MCIP1; ADAPT78
相關(guān)類別: 一抗
儲 存: 冷凍(-20℃)
宿 主: Rabbit
抗 原: RCAN1
反應(yīng)種屬: Human, Mouse
標(biāo) 記 物: Unconjugate
克隆類型: rabbit polyclonal
技術(shù)規(guī)格
|
Background: |
The protein encoded by this gene interacts with calcineurin A and inhibits calcineurin-dependent signaling pathways, possibly affecting central nervous system development. This gene is located in the minimal candidate region for the Down syndrome phenotype, and is overexpressed in the brain of Down syndrome fetuses. Chronic overexpression of this gene may lead to neurofibrillary tangles such as those associated with Alzheimer disease. Three transcript variants encoding three different isoforms have been found for this gene. |
|
Applications: |
ELISA, WB, IHC |
|
Name of antibody: |
RCAN1 |
|
Immunogen: |
Synthetic peptide of human RCAN1 |
|
Full name: |
regulator of calcineurin 1 |
|
Synonyms: |
CSP1; DSC1; RCN1; DSCR1; MCIP1; ADAPT78 |
|
SwissProt: |
P53805 |
|
ELISA Recommended dilution: |
2000-5000 |
|
IHC positive control: |
Human liver cancer and Human brain |
|
IHC Recommend dilution: |
50-200 |
|
WB Predicted band size: |
28 kDa |
|
WB Positive control: |
Mouse heart and brain tissue |
|
WB Recommended dilution: |
500-2000 |

 購物車
購物車 幫助
幫助
 021-54845833/15800441009
021-54845833/15800441009